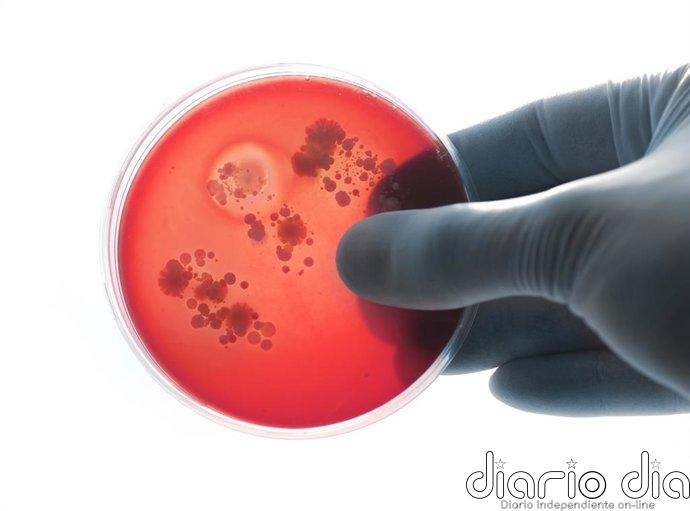
La meningitis sigue siendo una amenaza global: más de 250.000 muertes en 2023 pese al avance de las vacunas

La meningitis sigue siendo una amenaza global: más de 250.000 muertes en 2023 pese al avance de las vacunas
MADRID, 28 Mar. –
En 2023, a nivel mundial, 259.000 personas murieron a causa de la meningitis y 2,5 millones se infectaron con la enfermedad, según un estudio publicado en ‘The Lancet Neurology’ por el grupo internacional de investigación GBD 2019 Meningitis and Antimicrobial Resistance Collaborators.
Si bien las tasas de mortalidad e infección han disminuido significativamente desde 1990, el progreso es insuficiente para alcanzar los objetivos de la Organización Mundial de la Salud (OMS) de reducir las infecciones en un 50 por ciento y las muertes en un 70 por ciento para 2030.
La meningitis es la principal causa infecciosa de discapacidades neurológicas a nivel mundial. Desde el año 2000, la amplia implementación mundial de la vacunación ha reducido considerablemente el número de infecciones y muertes tanto en países de altos como de bajos ingresos; sin embargo, el progreso es menor que el de otras enfermedades prevenibles mediante vacunación.
Este estudio proporciona la evaluación global más completa de la meningitis hasta la fecha. Sugiere que, en 2023, a nivel mundial, 259.000 personas murieron a causa de la meningitis y 2,5 millones se infectaron con la enfermedad, siendo los principales factores de riesgo de muerte el bajo peso al nacer, seguido del parto prematuro y la contaminación del aire (tanto doméstica como atmosférica).
DÓNDE GOLPEA MÁS FUERTE LA ENFERMEDAD
La carga de morbilidad siguió siendo desproporcionadamente alta en los países de bajos ingresos, especialmente en el cinturón africano de la meningitis, donde Nigeria, Chad y Níger registraron las tasas más elevadas de mortalidad e infección. ‘Streptococcus pneumoniae’, ‘Neisseria meningitidis’, ‘enterovirus no poliomielíticos’ y otros virus fueron las principales causas de muerte, mientras que los enterovirus no poliomielíticos provocaron la mayoría de los casos.
Los autores señalan que es fundamental intensificar los esfuerzos, incluyendo la ampliación de los programas de vacunación, una mejor gestión del uso de antibióticos, la mejora del acceso a la atención médica y el fortalecimiento del diagnóstico y la vigilancia de la meningitis, para lograr una mayor reducción de la enfermedad a nivel mundial.
CL11








